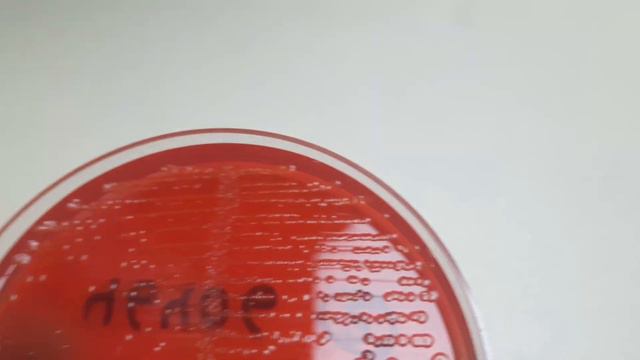
E. coli Colony Morphology смотреть онлайн

Автор: Открытие Знаний Страница 2

я не знаю что сказать

Для курса «Гостиничный сервис», лекция 9.
E. coli Colony Morphology

СНИМАЕМ ЗАЖИМ ПРИ ПЕНИИ 2. Эффективное упражнение

Крольчонок облысел.

Нет Армии победоносной ....

А вы знали что я есть в music.ly

Anna Nicole Smith Photogallery

если вы хотели 2 часть про Minecraft но стив не хочет говорить но еще он сминил ник на нур

Shift + Home in MS Word

HIS 102 | Chapter 23 | 4/19/23

CRADLE | ДОБИВАЮСЬ ЖЕНЩИНУ ПОДАРКАМИ

Dance for Camera - Music Collab Final

Геометрия 2. Лекция 8. Левин А. М.

♠•|опоздали...|•∆Пиковые∆•♠#1au_13k #13_карт #пиковару

Fix Windows 10 Update Error Code 0x800f0986 (Solved)

Судебное разбирательство по делу В.Азясева – в особом порядке и закрытом режиме

Взрослый кот ухаживает за котёнком!!!

Burger King

Копия видео "Mafia III: Definitive Edition Прохождение # 4"

Minecraft Caindo a 0 fps? Veja Aqui Como Resolver

10 клас. Арени (Ароматичні сполуки). Бензен: хімічні властивості, добування.

ЛАРИН / ОБЫСКИ У NEMAGIA НЕМАГИЯ ТИНЬКОВ БЕСПРЕДЕЛИТ

0.99ct негретый розовый сапфир
За каждым успешным каналом стоит личность, идея и сотни часов кропотливого труда. Если вы здесь, значит, автор «Открытие Знаний» уже сумел зацепить ваше внимание своим уникальным стилем или подачей. А мы на RUVIDEO позаботились о том, чтобы вы могли изучить весь архив его работ в максимально комфортных условиях — без лишней суеты и преград.
Почему за работами канала «Открытие Знаний» так интересно наблюдать? Всё просто: это честный контент, который находит отклик в сердцах зрителей. На нашем ресурсе вы можете смотреть онлайн все видео любимого автора бесплатно и в хорошем качестве. Нам важно, чтобы вы видели каждую деталь и слышали каждый нюанс, поэтому мы используем только стабильные плееры из открытых источников Rutube.
Следите за новинками канала, пересматривайте старые шедевры и открывайте для себя новые грани творчества «Открытие Знаний». Мы постоянно обновляем ленту, чтобы у вас под рукой всегда были самые свежие выпуски. Никаких сложных регистраций — только вы и творчество, которое вдохновляет. Приятного вам путешествия по миру авторского контента на RUVIDEO!
Видео взято из открытых источников Rutube. Если вы правообладатель, обратитесь к первоисточнику.